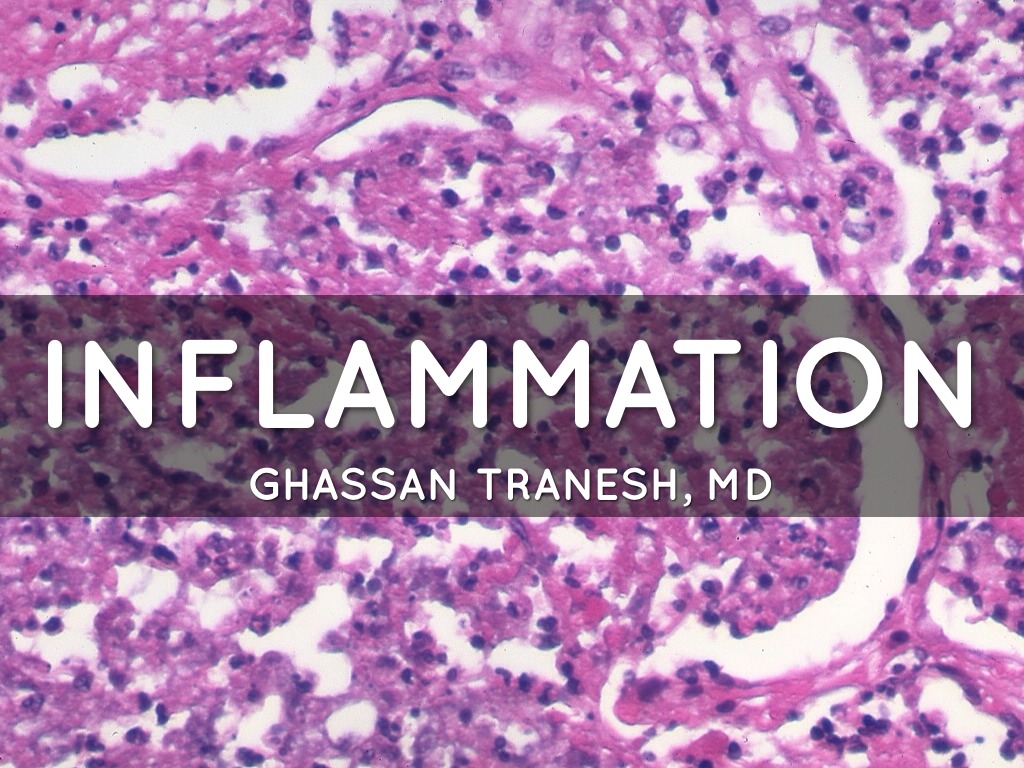
Inflammation

You’ve Reached Your Account Limit!
Your Haiku Deck plan includes one Haiku Deck. Please upgrade to one of our paid plans in order to create or edit additional decks. You’ll love the additional features Haiku Deck subscribers get and you’ll be helping to support Haiku Deck’s mission — to make it 10 times faster and easier for you to create presentations that are 10 times better.
Education Presentation Templates
Educators love the simplicity of Haiku Deck while students find it fun and easy to use. Try one of our templates for your class, lesson plan, or school project. Get started by copying one of our templates so you can tailor the content for your presentation needs.
To get started, walk through our Lesson Plan Template which you can copy and customize after creating your own account. Otherwise, explore the templates below and find inspiration for your next presentation.
Presentations created 11 May 2014
Other Haiku Deck Favorites

Bringing Staff and Students together to develop digital skills
byFiona Harvey
|3966 views
Business, Education, Inspiration, Science and Technology

Dates are GMT







 Get Haiku Deck Pro
Get Haiku Deck Pro Saving your changes...
Saving your changes...